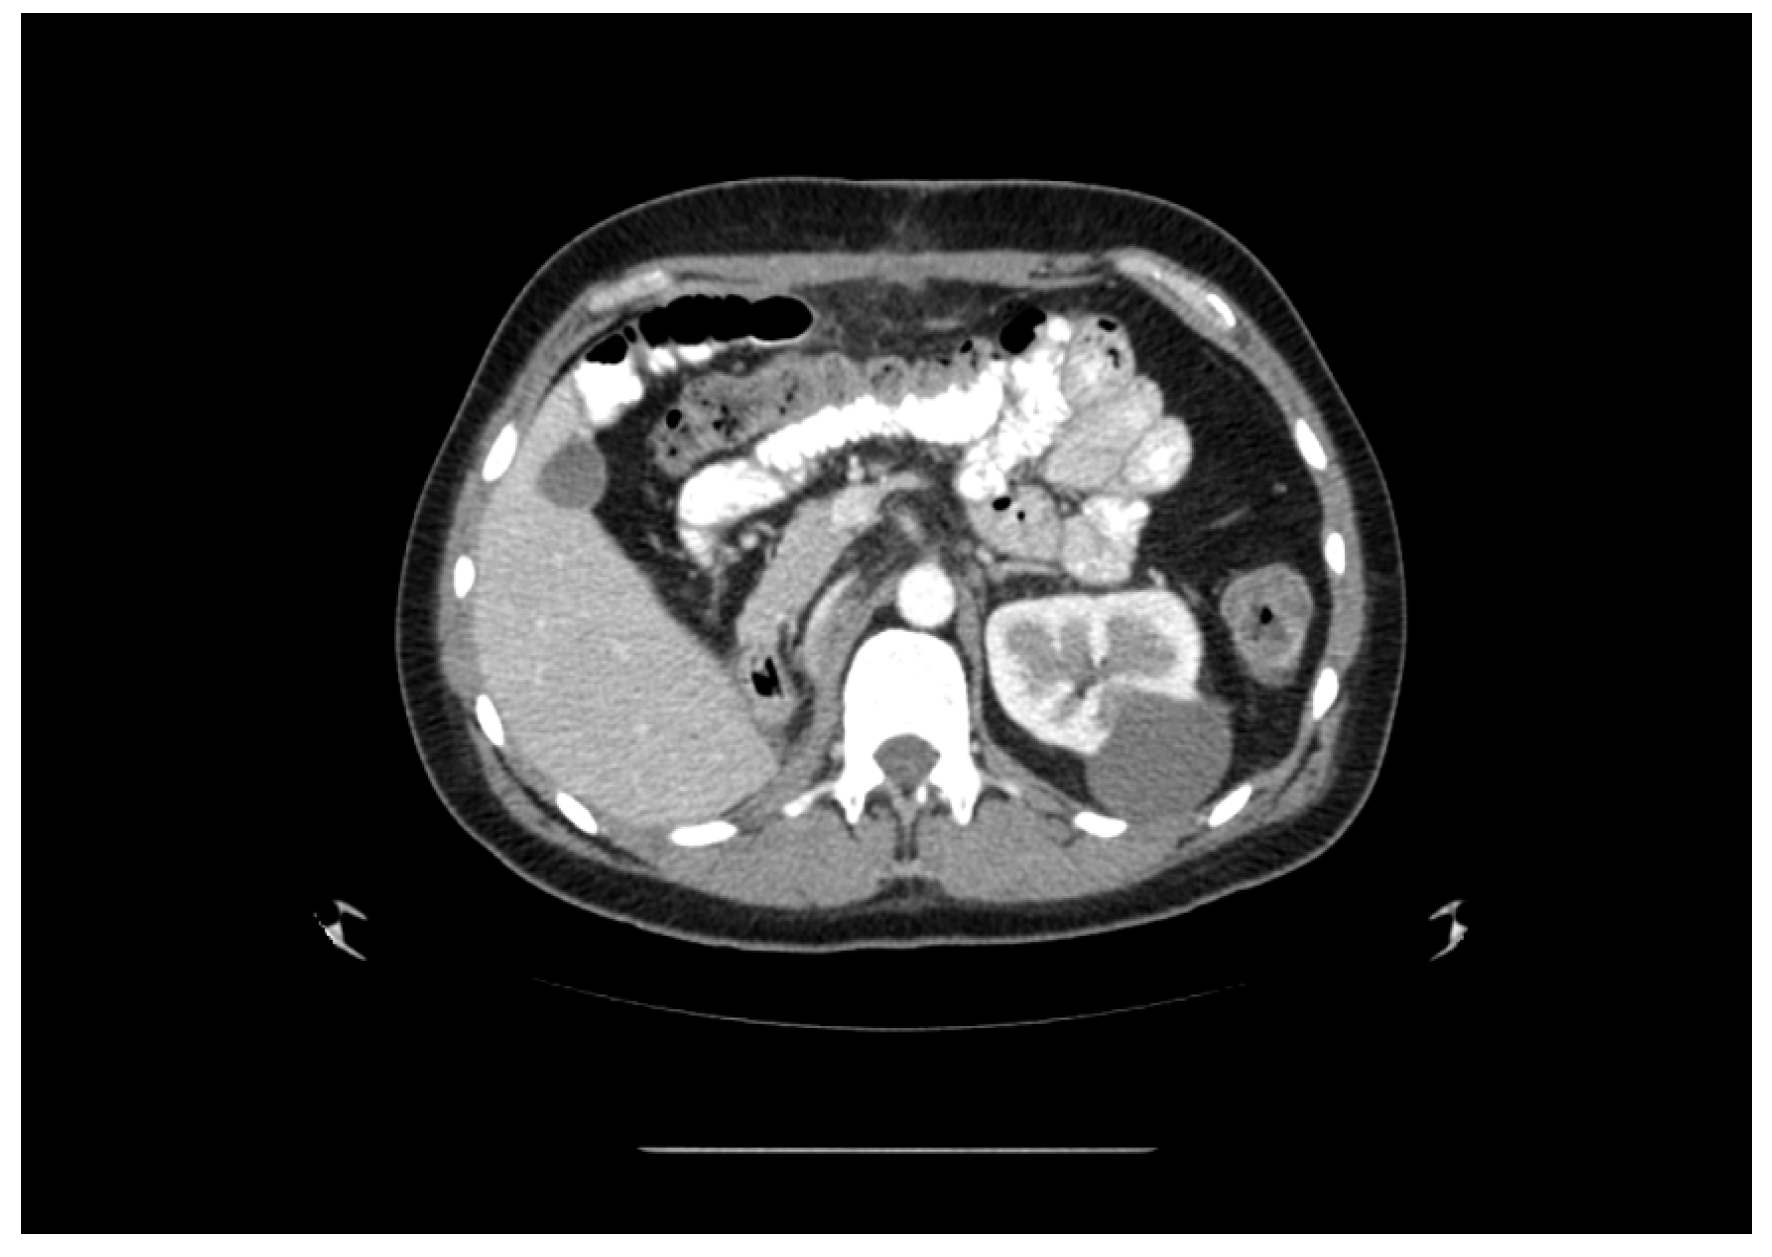
Medicina 60 01553 g003

Synchronous Seminoma of Testis and Renal Cell Carcinoma: A Rare Case Report
Abstract
1. Introduction
2. Case Presentation
3. Discussion
4. Conclusions
Author Contributions
Funding
Institutional Review Board Statement
Informed Consent Statement
Data Availability Statement
Acknowledgments
Conflicts of Interest
Correction Statement
References
- Marko, J.; Wolfman, D.J.; Aubin, A.L.; Sesterhenn, I.A. Testicular Seminoma and Its Mimics: From the Radiologic Pathology Archives. Radiographics 2017, 37, 1085. [Google Scholar] [CrossRef] [PubMed]
- Oldenburg, J.; Berney, D.; Bokemeyer, C.; Climent, M.; Daugaard, G.; Gietema, J.; De Giorgi, U.; Haugnes, H.; Huddart, R.; Leão, R.; et al. Testicular seminoma and non-seminoma: ESMO-EURACAN Clinical Practice Guideline for diagnosis, treatment and follow-up 5 behalf of the ESMO Guidelines Committee. Ann. Oncol. 2022, 33, 362–375. [Google Scholar] [CrossRef] [PubMed]
- Mo, L.; Yu, Z.; Lv, Y.; Cheng, J.; Yan, H.; Lu, W.; Su, C.; Ling, Q.; Mo, Z. Single-Cell RNA Sequencing of Metastatic Testicular Seminoma Reveals the Cellular and Molecular Characteristics of Metastatic Cell Lineage. Front. Oncol. 2022, 12, 871489. [Google Scholar] [CrossRef] [PubMed] [PubMed Central]
- Bahadoram, S.; Davoodi, M.; Hassanzadeh, S.; Bahadoram, M.; Barahman, M.; Mafakher, L. Renal cell carcinoma: An overview of the epidemiology, diagnosis, and treatment. G. Ital. Nefrol. 2022, 39, 2022. [Google Scholar] [PubMed]
- Capitanio, U.; Bensalah, K.; Bex, A.; Boorjian, S.A.; Bray, F.; Coleman, J.; Gore, J.L.; Sun, M.; Wood, C.; Russo, P. Epidemiology of Renal Cell Carcinoma. Eur. Urol. 2019, 75, 74–84. [Google Scholar] [CrossRef]
- Huszno, J.; Kołosza, Z. Checkpoint Kinase 2 (CHEK2) Mutation in Renal Cell Carcinoma: A Single-Center Experience. J. Kidney Cancer VHL 2018, 5, 19. [Google Scholar] [CrossRef]
- Davis, B.E.; Sogani, P.C.; Herr, H.W. Association of Primary Germ Cell Tumor of the Testis and Renal Cell Carcinoma. J. Urol. 1993, 150, 1489–1491. [Google Scholar] [CrossRef]
- Deshmukh, S.; Fulare, S.; Chowksey, S.; Soitkar, A.; Nagre, A.; Mundle, A. Synchronous mixed germ cell tumor of testis and renal cell carcinoma: A rare presentation. Int. J. Surg. Case Rep. 2019, 60, 123–125. [Google Scholar] [CrossRef]
- Dieckmann, K.P.; Loy, V.; Klan, R. Seminoma Testis and Concomitant Ipsilateral Renal Cell Carcinoma. Urol. Int. 1988, 43, 49–52. [Google Scholar] [CrossRef]
- Basic-Jukic, N.; Kirincich, J.; Jelakovic, B.; Kastelan, Z. Multiple Primary Malignancies in Renal Transplant Recipients: A Single Centre Retrospective Cohort Study. Kidney Blood Press. Res. 2018, 43, 1034–1041. [Google Scholar] [CrossRef]
- Lu, M.; Zhang, X.; Chu, Q.; Chen, Y.; Zhang, P. Susceptibility Genes Associated with Multiple Primary Cancers. Cancers 2023, 15, 5788. [Google Scholar] [CrossRef] [PubMed]
- Pliszka, A.; Rajda, S.; Wawrzyniak, A.; Walocha, J.; Polguj, M.; Wysiadecki, G.; Clarke, E.; Golberg, M.; Zarzecki, M.; Balawender, K. Testicular Metastasis from Renal Cell Carcinoma: A Systematic Review. J. Clin. Med. 2023, 12, 5636. [Google Scholar] [CrossRef] [PubMed]
- Naimi, A.; Hajiahmadi, S.; Sohrabi, H. Metastatic Seminoma Presenting in Kidney and Cervical Lymph Nodes after a 25-Year Interval: A Case Report and Literature Review. Case Rep. Oncol. 2023, 16, 1508–1517. [Google Scholar] [CrossRef] [PubMed]
- Dieckmann, K.P.; Wegner, H.; Krain, J. Multiple Primary Neoplasms in Patients with Testicular Germ Cell Tumor. Oncology 1994, 51, 450–458. [Google Scholar] [CrossRef] [PubMed]
- Robinson, D.; Møller, H.; Horwich, A. Mortality and incidence of second cancers following treatment for testicular cancer. Br. J. Cancer 2007, 96, 529–533. [Google Scholar] [CrossRef] [PubMed][Green Version]
- Bokemeyer, C.; Schmoll, H.J. Treatment of testicular cancer and the development of secondary malignancies. J. Clin. Oncol. 1995, 13, 283–292. [Google Scholar] [CrossRef]
- Kim, B.J.; Kim, J.H.; Kim, H.S.; Zang, D.Y. Prognostic and predictive value of VHL gene alteration in renal cell carcinoma: A meta-analysis and review. Oncotarget 2017, 8, 13979–13985. [Google Scholar] [CrossRef]
- Wang, A.; Papneja, A.; Hyrcza, M.; Al-Habeeb, A.; Ghazarian, D. Gene of the month: BAP1. J. Clin. Pathol. 2016, 69, 750–753. [Google Scholar] [CrossRef]
- Louie, B.H.; Kurzrock, R. BAP1: Not just a BRCA1-associated protein. Cancer Treat. Rev. 2020, 90, 102091. [Google Scholar] [CrossRef]
- Lindner, A.K.; Tulchiner, G.; Seeber, A.; Siska, P.J.; Thurnher, M.; Pichler, R. Targeting strategies in the treatment of fumarate hydratase deficient renal cell carcinoma. Front. Oncol. 2022, 12, 906014. [Google Scholar] [CrossRef]
- Hartman, T.R.; Demidova, E.V.; Lesh, R.W.; Hoang, L.; Richardson, M.; Forman, A.; Kessler, L.; Speare, V.; Golemis, E.A.; Hall, M.J.; et al. Prevalence of pathogenic variants in DNA damage response and repair genes in patients undergoing cancer risk assessment and reporting a personal history of early-onset renal cancer. Sci. Rep. 2020, 10, 13518. [Google Scholar] [CrossRef] [PubMed]

Disclaimer/Publisher’s Note: The statements, opinions and data contained in all publications are solely those of the individual author(s) and contributor(s) and not of MDPI and/or the editor(s). MDPI and/or the editor(s) disclaim responsibility for any injury to people or property resulting from any ideas, methods, instructions or products referred to in the content. |
© 2024 by the authors. Published by MDPI on behalf of the Lithuanian University of Health Sciences. Licensee MDPI, Basel, Switzerland. This article is an open access article distributed under the terms and conditions of the Creative Commons Attribution (CC BY) license (https://creativecommons.org/licenses/by/4.0/).
Share and Cite
Auskalnis, S.; Janciauskiene, R.; Rimsaite, U.; Alksnyte, A.; Ugenskiene, R. Synchronous Seminoma of Testis and Renal Cell Carcinoma: A Rare Case Report. Medicina 2024, 60, 1553. https://doi.org/10.3390/medicina60091553
Auskalnis S, Janciauskiene R, Rimsaite U, Alksnyte A, Ugenskiene R. Synchronous Seminoma of Testis and Renal Cell Carcinoma: A Rare Case Report. Medicina. 2024; 60(9):1553. https://doi.org/10.3390/medicina60091553
Chicago/Turabian StyleAuskalnis, Stasys, Rasa Janciauskiene, Urte Rimsaite, Aurelija Alksnyte, and Rasa Ugenskiene. 2024. "Synchronous Seminoma of Testis and Renal Cell Carcinoma: A Rare Case Report" Medicina 60, no. 9: 1553. https://doi.org/10.3390/medicina60091553
APA StyleAuskalnis, S., Janciauskiene, R., Rimsaite, U., Alksnyte, A., & Ugenskiene, R. (2024). Synchronous Seminoma of Testis and Renal Cell Carcinoma: A Rare Case Report. Medicina, 60(9), 1553. https://doi.org/10.3390/medicina60091553
